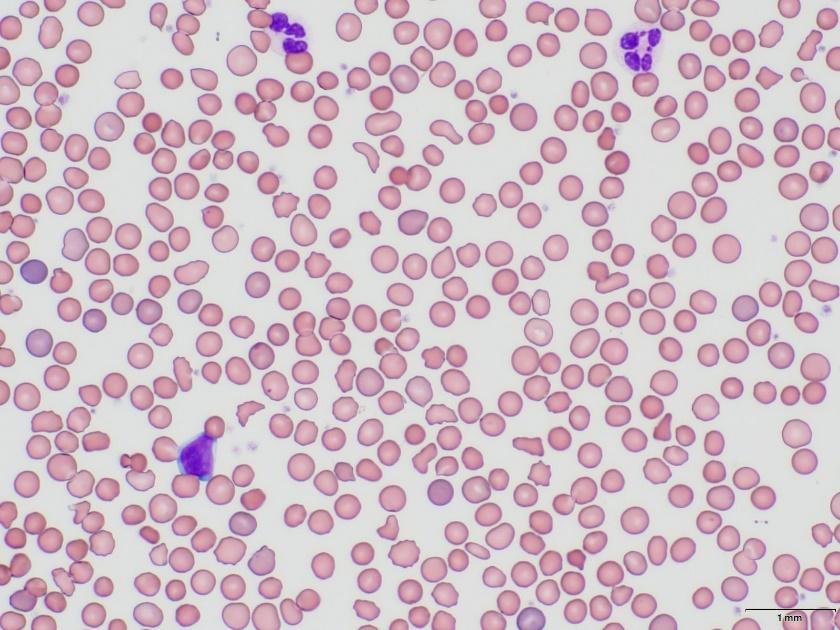

小児の貧血
貧血は,「健常人に比べてヘモグロビン(Hb)値または循環赤血球量が低いこと」を言います。約20%ほどは小児期に貧血を経験すると言われ,とても頻度の高い疾患です。原因は多岐に渡り,最も頻度が多いのは鉄欠乏性貧血ですが,なかには緊急・専門的な治療を要する疾患や,生涯つきあっていく必要のある疾患もあるため,鑑別診断は重要です。
原因・機序
赤血球は骨髄で産生されて成熟した後に,全身を循環して組織に酸素を運ぶ役割をしています。そのどこかの過程がうまくいかないことで貧血を生じるため,貧血の発症機序は大きく以下の4つに分類されます。

症状
一般的な貧血の症状として,組織への酸素供給低下によるもの(皮膚蒼白,倦怠感,息切れ,めまい,易疲労感,頭痛)と,その代償機構によるもの(動悸,頻呼吸)があります。
また,疾患に特徴的なものとしては,鉄欠乏性貧血では易刺激性・集中力低下・異食症,溶血性疾患では黄疸・褐色尿・胆石・脾腫,悪性疾患や全身疾患に伴う貧血では発熱・リンパ節腫脹などがみられることもあります。
緩徐に貧血が進行した場合には症状が出づらく,偶然行った血液検査で指摘されることもあります。
診断
一般にヘモグロビン値で判定しますが,その基準値は年齢・性別により異なります。

鑑別診断
患者さんからお聞きした情報(周産期歴(貧血,黄疸の有無),成長発達歴(外表奇形,成長曲線),家族歴(遺伝性疾患の有無,貧血・黄疸の既往者,血族・国際結婚),生活歴(食事・スポーツなど),薬剤使用,全身疾患の有無など)と,必要に応じて行った検査(血液検査・尿検査,画像検査,骨髄検査)の所見を合わせて総合的に診断を行います。
まずは,赤血球の形態,網赤血球数(造血の程度を反映している),平均赤血球容積(MCV:赤血球の大きさを示す)によって大まかに鑑別をつけることができます。
![]()
治療
原因疾患によって治療は異なるため,診断を確定した後に必要な治療を行います。
輸血療法
急激で重症度の高い貧血,回復までに時間がかかる場合の補充)
投薬治療
ステロイド,その他免疫抑制剤(特発性再生不良性貧血),鉄剤・葉酸・ビタミン,蛋白同化ホルモン,エリスロポエチン(造血の補助として必要な場合)
食事療法
造血に必要な材料を摂取
脾臓摘出
溶血性疾患で赤血球を壊す場所を摘出することがある
骨髄移植
悪性疾患,骨髄不全などで原疾患治療が必要な時
全身疾患の治療
原疾患の治療(悪性疾患では化学療法など),薬剤の中止など
その他
輸血療法や疾患によって鉄過剰が起こる場合には鉄キレート剤の内服。